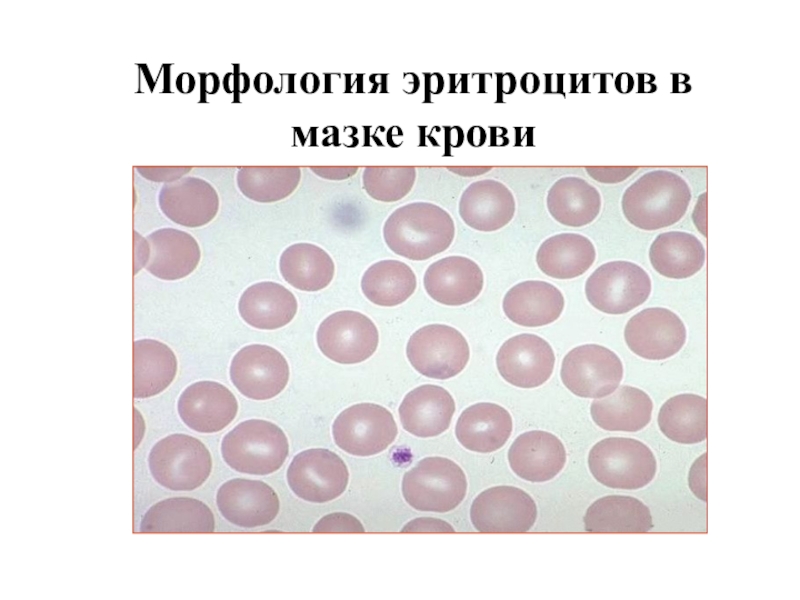
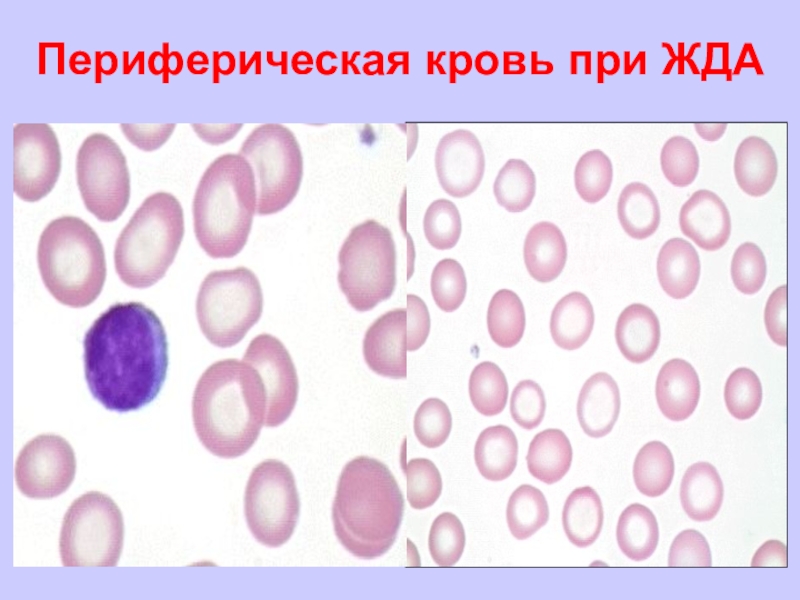
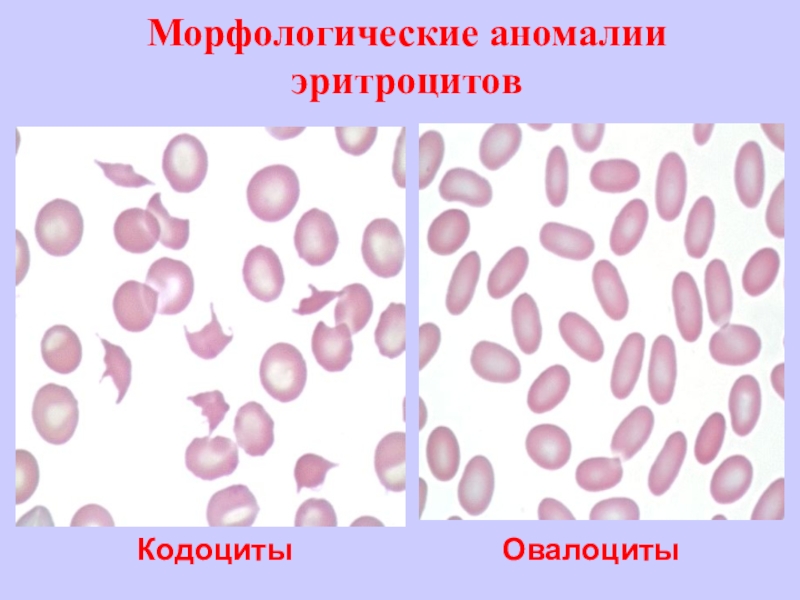
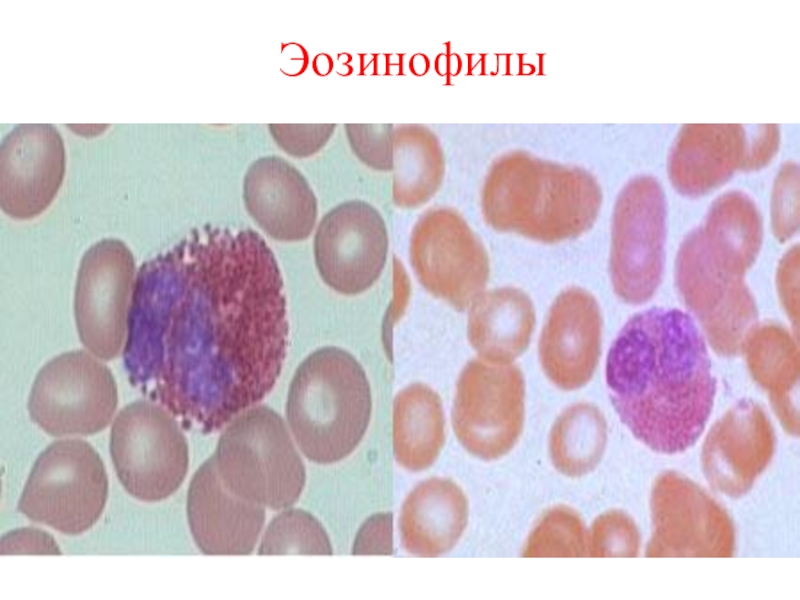
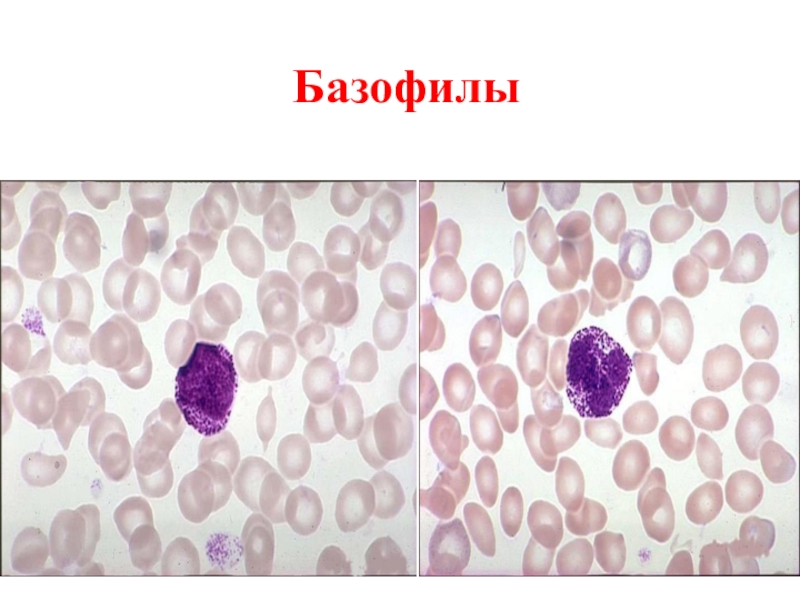

Слайд 1 ОБЩИЙ АНАЛИЗ КРОВИ И ЕГО ДИАГНОСТИЧЕСКОЕ ЗНАЧЕНИЕ
Слайд 2 Необходимо определить следующие показатели крови:
Количество гемоглобина
Гематокрит
Количество эритроцитов
Цветовой показатель
Эритроцитарные индексы
Количество лейкоцитов
Подсчёт лейкоцитарной
формулы
Количество тромбоцитов
Скорость оседания эритроцитов
Слайд 3Гематологические анализаторы
Слайд 5Гемоглобин – основной дыхательный пигмент и главный компонент эритроцитов, выполняющий
важные функции в организме человека: перенос кислорода от легких в
ткани, выведение углекислого газа из организма и регуляция кислотно-основного состояния крови. Гемоглобин – красный пигмент крови человека и животных, относящийся к хромопротеидам.
Слайд 6Hb представляет собой сложный белок, белковый компонент в котором представлен
глобином, небелковый – простетической группой. В состав Hb входят две
пары полипептидных цепей двух типов. Гемоглобины различных видов имеют различия во вторичной, третичной и четвертичной структуре, поэтому свойства их индивидуальны, В крови человека имеются Hb различных типов, отличающиеся по строению. Основным Hb крови взрослого человека является HbA (97%), а также HbA2 (2,5%). Кроме того, в крови взрослого человека содержится до 1,5% HbF.
Слайд 7В норме концентрация гемоглобина у женщин - 120 - 140
г/л, у мужчин - 130 - 160 г/л.
Слайд 8Клинико-диагностическое значение определения концентрации гемоглобина в крови
Повышение содержания Hb в
крови наблюдается при первичных и вторичных эритремиях, обезвоживании.
Снижение концентрации
Hb в крови имеет место при анемиях, гипергидратации.
Слайд 9Эритроциты
Число циркулирующих эритроцитов составляет 25-30х1012 клеток, что составляет около 2
л (кг)
Длительность циркуляции – 100-120 дней
Диаметр 7-8 мкм, площадь
поверхности –140 мкм2, объем 90 мкм3
Функции- участие в газообмене, поддержание буферного ионно-водного равновесия, в иммунной защите
Более 250 антигенов эритроцитов
Слайд 11Морфология эритроцитов в мазке крови
Слайд 12Определение количества эритроцитов в крови
Подсчет количества эритроцитов может проводиться,
в специальной камере под микроскопом, а затем производят пересчет полученного
результата на 1 л крови
Слайд 13КОЛИЧЕСТВО ЭРИТРОЦИТОВ (RBC)
в зависимости от возраста
(данные ВОЗ 2001г.)
новорождённые 5 -
7 · 10 12/л
1 месяц 4,5 - 5,3 · 10
12/л
3 месяца 3,8 - 4,6 · 10 12/л
6 месяцев 3,8 - 4,6 · 10 12/л
12 месяцев 3,9 - 4,7 · 10 12/л
до 6 лет 3,66 - 5,08 · 10 12/л
> 6 лет (мальчики) 4 - 5,12 · 10 12/л
> 6 лет (девочки) 3,99 - 4,41 · 10 12/л
Слайд 14Изменение эритроцитов в мазке крови
При просмотре мазка оцениваются величина, форма
и степень насыщения эритроцитов гемоглобином.
Эритроциты диаметром 7,2-7,5 микрон называются
нормоцитами, диаметром менее 6,7 микрон - микроцитами, более 7,7 микрон - макроцитами, свыше 9,5 микрон - мегалоцитами.
Анизоцитоз - изменение размера эритроцитов (микро-, макро-мегалоцит, шизоциты - мелкие фрагменты эритроцитов).
В норме эритроциты нормохромные, имеют равномерную окраску с незначительным просветлением в центре. Появление эритроцитов с более широкой неокрашенной центральной частью - гипохромия - обусловлена снижением концентрации гемоглобина в эритроците. Равномерная интенсивная окраска эритроцитов - гиперхромия - связана с толщиной и повышенным насыщением эритроцитов гемоглобином. Анизохромия - присутствие в мазках крови гипо- и гиперхромных эритроцитов.
Слайд 15Пойкилоцитоз - изменение формы эритроцитов (овалоцит, акантоцит, стоматоцит, эхиноцит, мишеневидные
и серповидные клетки, сфероцит и др.).
Преобладание в мазке эритроцитов малых
размеров - микроцитоз наблюдается при железодефицитной анемии. Макроцитоз - появление крупных эритроцитов - при В12-фолиево-дефицитной анемии. При этом заболевании могут появляться мегалоциты - крупные овальные гиперхромные эритроциты, образующиеся при созревании мегалобластов.
При ряде анемий встречается анизоцитоз (появление эритроцитов неодинаковых по размерам) и пойкилоцитоз (появление эритроцитов неправильной формы). Если эритроциты недостаточно насыщены гемоглобином, они слабо воспринимают краску и становятся гипохромными (при железодефицитной анемии). При В12-фолиево-дефицитной анемии эритроциты – гиперхромные.
Слайд 16Аномалии эритроцитов
Анизоцитоз
Макроцитоз
Пойкилоцитоз
Гиперхромия
Слайд 18В-12 дефицитная анемия
макроцитоз, гиперхромия эритроцитов
Слайд 19Морфологические аномалии эритроцитов
Овалоциты
Кодоциты
Слайд 20Морфологические аномалии эритроцитов
Стоматоциты
Эхиноциты
Слайд 21 Аномалии эритроцитов
Серповидно-клеточная
деформация эритроцитов
Мишеневидные
эритроциты
Слайд 22Клинико-диагностическое значение эритроцитоза
Эритроцитоз - увеличение количества эритроцитов в крови
(более 5,0x1012/л), может быть реактивный (вторичный или симптоматический) и опухолевый
(первичный).
Реактивный эритроцитоз развивается вследствие гиперпродукции эритропоэтина в ответ на тканевую гипоксию, причины которой могут быть различные (хронические обструктивные заболевания легких, врожденные пороки сердца); опухоли (рак почек, надпочечников, гепатома, аденома и киста гипофиза); поликистоз почек, стеноз почечных артерий, гидронефроз и т.д.
Слайд 23Клинико-диагностическое значение эритроцитоза
Эритроцитозы вторичные (относительные) развиваются у лиц с
избыточной массой тела, артериальной гипертонией и неврастенией, при постоянном приеме
диуретиков; в постинфарктном периоде у больных ИБС; при повышение в крови уровня окиси углерода у курильщиков, длительной адинамии, в частности у космонавтов. Эритроцитоз, как правило, не достигает очень высоких цифр и сопровождается небольшим ретикулоцитозом. У лиц, находящихся в условиях высокогорья или длительного периода адинамии, возможно появление гипохромии, небольшого анизоцитоза и мишеневидных эритроцитов.
Слайд 24Клинико-диагностическое значение эритроцитопении
Эритроцитопения - снижение числа эритроцитов (менее 4,0x1012/л)
в единице объема крови. Эритроцитопения может развиться вследствие: кровопотери, нарушенного
кровеобразования (апластические анемии), повышенного гемолиза эритроцитов (эритроцитопатии, энзимопатии, гемоглобинопатии); радиационного облучения; заболеваний печени, почек; гиперспленического синдрома; дефицита гемопоэтических факторов (железо, витамин В12, фолиевая кислота); гипергидратации при увеличении объема циркулирующей плазмы; инфекциях, в первую очередь, хронических (туберкулез).
Слайд 25Современные анализаторы крови позволяют оценить гистограмму, т.е. распределение эритроцитов по
их объему, которое наглядно иллюстрирует распределение клеток по размерам и
позволяет выявить аномальные популяции: микроцитов, макроцитов, охарактеризовать степень анизоцитоза. Распределение эритроцитов по объему у здоровых людей имеет унимодальный характер.
Слайд 26Определение скорости оседания эритроцитов (СОЭ)
СОЭ - одно из важнейших
и наиболее распространенных лабораторных исследований, и должно быть проведено не
позже двух часов после взятия крови. Более долгий промежуток отражается на результатах иследования.
СОЭ - это процесс разделения свежевыпущенной крови с примесью антикоагулянтов на два слоя: нижний - эритроциты, верхний - плазма и лейкоциты. СОЭ выявляет изменения в соотношении белковых компонентов плазмы крови, а также числа и объема эритроцитов при различных заболеваниях.
Слайд 27В нашей стране наиболее распространен микрометод в модификации Панченкова. При
определении СОЭ количество крови должно в 4 раза превышать объем
реактива. Обычно кровь смешивают с раствором цитрата натрия (1 часть реактива и 4 части крови), при оценке СОЭ за постоянную величину чаще всего принимают время (1 час), относительно которого оценивают переменную величину - оседание.
Определение производят в специально градуированных капиллярных пипетках, имеющих просвет, равный 1 мм, и длину 100 мм.
Слайд 28В норме скорость оседания эритроцитов у женщин составляет 2-15 мм
в час, у мужчин - 1-10 мм в час, у
новорожденных 0,9 мм/ч в первый день и до 4,0±2,1 мм/ч на второй неделе. У детей первого года жизни СОЭ колеблется от 4 - 10 мм/ч, в дальнейшем варьирует от 5 до11 мм/ч.
Слайд 29Клинико-диагностическое значение определения СОЭ
Увеличение СОЭ наблюдается при различных воспалительных
процессах, острых и хронических инфекциях, при инфаркте миокарда, опухолях, после
кровопотери, оперативных вмешательств. СОЭ увеличивается при беременности, приеме многих стероидных гормонов (эстрогенов, глюкокортикоидов) и некоторых лекарственных препаратов (например, салицилаты). Увеличение СОЭ наблюдается при гиперхолестеринемии.
Особенно выраженное ускорение СОЭ (60-80 мм/ч) характерно для парапротеинемических гемобластозах (множественная миелома, макроглобулинемия Вальденстрема, острый плазмобластный лейкоз и др.) и симптоматических парапротеинемиях, сопутствующих злокачественным новообразованиям, хроническому гепатиту, циррозу печени, туберкулезу, амилоидозу, коллагенозам.
Слайд 30Клинико-диагностическое значение определения СОЭ
Замедление СОЭ наблюдается при серповидноклеточной анемии, сфероцитозе,
акантоцитозе, микроцитозе, полицитемия, гипофибриногенемия, кахексии, эритремии, семейном и симптоматическом эритроцитозе,
застойной сердечной недостаточности.
Слайд 31Лейкоциты - белые кровяные тельца - играют главную роль в
противомикробной защите организма. Гранулоциты фагоцитируют микробы и разрушают их с
помощью ферментов, заключенных в гранулах, лимфоциты вырабатывают антитела. И обеспечивают иммунные реакции организма.
По структуре ядра нейтрофилы, базофилы и эозинофилы делятся на сегментоядерные и палочкоядерные.
Слайд 32 Нейтрофилы
Палочко-ядерный
Сегменто-ядерный
Слайд 33Нейтрофилы
Периферическая кровь
Длительность циркуляции – 8-10 часов
Ткани
Длительность пребывания –4-5 суток
Слайд 35Кинетика эозинофилов
Зрелые эозинофилы выходят в сосудистое русло и циркулируют там
до 10 часов, составляя 0,5% от всех лейкоцитов крови
В
тканях срок жизни эозинофилов около 6 суток. Тканевые эозинофилы распределены неравномерно, наибольшее их количество выявляется в тканях, соприкасающихся с внешней средой –подслизистый слой дыхательного пищеварительного и мочеполового тракта.
Тканевые эозинофилы повторно в сосудистое русло не возвращаются и разрушаются путем апоптоза в тканях.
Слайд 36Гранулы эозинофилов
Главный щелочной протеин – обладает цитотоксичностью, повреждает некоторые личинки
гельминтов, эпителиальные ткани, нейтрализует гепарин
Кислая фосфатаза
Арилсульфатаза –ингибирует анафилактоидные вещества, уменьшая
реакцию гиперчувствительности немедленного типа
Простагландины – угнетают дегрануляцию тучных клеток
Гистаминаза, фосфолипаза – инактивируют гистамин, гепарин, уменьшая последствия секреции тучных клеток
Коллагеназа
Эластаза
Глюкоронидаза
Эозинофильная пероксидаза – бактерицидная активность
Слайд 37Функции эозинофилов
Эозинофил – основная эффекторная клетка в развитии инфекционных, паразитарных,
аллергических, аутоиммунных и онкологических заболеваний
Слайд 39Морфология базофилов
Размер клетки 10-15 мкм
Ядро: расположение –центральное,форма- 2-3 сегмента (чаще
фигура трефового туза), цвет ядра –лилово-синий, хроматин- грубый, закрыт гранулами.
Цитоплазма
– относительные размеры значительные, цвет - интенсивно розовый, гранулы большие, грубые, лиловые или синевато-черные
Слайд 40Базофилы
Описаны в 1891 году, но до сих пор изучены недостаточно
по сравнению с др. гранулоцитам из-за малочисленности
Дифференцировка базофилов в костном
мозге длится 1,5-5 суток, ростовой фактор для базофилов – ИЛ-3, ИЛ-4
Имеют общего предшественника с тучной клеткой
Период полужизни в крови 6 часов
Миграция в ткани (Локализуются в серозных оболочках, селезенке, эпителии, подслизистом слое желудочно-кишечного, дыхательного и урогенитального трактов, коже, соединительной ткани, окружающей капилляры.
Слайд 41Функции базофилов
Реакции, определяемые базофилами и тучными клетками, необходимы для формирования
воспалительного процесса как главной реакции иммунной системы на чужеродные агенты
Слайд 43Моноциты вместе с макрофагами объединяют в систему мононуклеарных фагоцитов. Мононуклеарные
фагоциты принимают активное участие в неспецифической защите от патогенных микроорганизмов,
инициации специфического иммунного ответа, в метаболизме липидов и железа, регуляции кроветворения, гемостазе. Мононуклеарные фагоциты секретируют цитокины и другие биологически активные вещества, регулирующие пролиферацию, дифференцировку и функциональную активность различных клеток.
Слайд 45Основная функция Т-лимфоцитов - реализация клеточного иммунного ответа.
Главная функция В-лимфоцитов
- реализация гуморального иммунного ответа. Основой его служит активация В-клеток
и их дифференцировка в антителообразующие плазматические клетки.
Слайд 46 Определение количества лейкоцитов
Взятие и разведение крови осуществляется пробирочным методом.
В качестве разводящей жидкости используют 3 - 5% раствор уксусной
кислоты (уксусная кислота лизирует эритроциты).
Необходимое разведение крови 1: 20. Для этого в пробирку вносят 0,4 мл разводящей жидкости и 0,02 мл крови. Поскольку лейкоцитов гораздо меньше, чем эритроцитов, для точности подсчет производят в 100 больших неразграфленных квадратах.
Количество лейкоцитов в 1 л крови рассчитывают по формуле:
А х 4000 х 20
Лейкоциты = -------------------------- х 106
1600
А - число лейкоцитов, сосчитанных в определенном количестве квадратов,
20 - разведение крови,
1600- количество малых квадратов,
1/4000 - объем малого квадрата.
В норме в 1 л крови взрослого человека содержится:
4.0- 8.8 х 109 лейкоцитов.
Слайд 47Нормы содержания лейкоцитов в крови
Слайд 48Причины лейкоцитоза
Лейкоцитоз может быть абсолютным и относительным
Относительный или перераспределительный
лейкоцитоз возникает вследствие сосудистых реакций с выселением лейкоцитов из кровяных
депо
– пищеварительный (особенно после белковой пищи),
- миогенный после мышечной работы или в результате судорог,
- симпатико-вегетативных воздействий - горячие и холодные ванны, эмоциональный фактор, беременность (смешанный характер лейкоцитоза)
Слайд 49Причины абсолютного лейкоцитоза
Абсолютный лейкоцитоз может быть функциональным и органическим
Функциональный лейкоцитоз
возникает вследствие стимуляции лейкопоэтической функции кроветворных органов в результате действия
специфических возбудителей и факторов воспаления, носит временный характер
Острые инфекционные процессы (кроме брюшного тифа, бруцеллеза, большинства вирусных инфекций)
Воспалительные заболевания (пневмония, плеврит и др.)
Гнойные процессы (сепсис,рожа, менингит и др)
Воздействие различных медикаментов – кортикостероидные препараты, интерлейкины, вакцины и сыворотки
Эндогенные интоксикации – инфаркт миокарда, обширные ожоги, Злокачественные опухоли, уремия
Экзогенные интоксикации – мышьяк, нитробензол, угарный газ и др
Воздействие ионизирующей радиации
Значительные кровопотери (особенно кровоизлияния в замкнутые полости)
Шоковые , послеоперационные состояния, эпилепсия
Органический лейкоцитоз- острые и хронические гемобластозы
Слайд 50Причины лейкопении
функциональные
Нейро-вегетативные влияния (преоблпадание тонуса парасимпатической нервной системы,голодание, астноневротический синдром,
во время глубокого сна, у стариков и истощенных лиц)
Бактериальные инфекции
(брюшной тиф, бруцеллез, затяжной септический эндокардит
Вирусные инфекции – грипп, корь, краснуха, вирусный гепатит,
Спленомегалия
Системная красная волчанка
органические
Агранулоцитоз
Гипо- и апластические состояния
Некоторые гемобластозы
Воздействие ионизирующей радиации
Слайд 51Подсчет лейкоцитарной формулы
Лейкоцитарной формулой называют процентное соотношение различных
форм лейкоцитов в крови. Лейкоцитарную формулу подсчитывают в окрашенных мазках.
Из множества предложенных окрасок наиболее распространенной является окраска по Романовскому-Гимзе.
Подсчитывают по 100 клеток у верхнего и нижнего края мазка, по которым затем вычисляется процентное соотношение между их отдельными видами и записывается лейкограмма (так как подсчет проводится на 200 клеток, результат делят пополам).
Слайд 52Нормы процентного соотношения отдельных форм
лейкоцитов в
крови здорового человека
Слайд 53Возрастные особенности лейкоцитарной формулы
в первый день - нейтрофилы составляют
60-70%, отмечается
левый сдвиг
со 2-ого дня - снижение нейтрофилов и повышение лимфоцитов
к 5-ому
дню - первый перекрест (44%)
к 5-6 месяцам - минимальное количество нейтрофилов (20-40%)
4-5 лет - второй перекрёст (44%)
после 5 лет - нарастание нейтрофилов в среднем на 2% в год до 65%
Слайд 54Нейтрофилез - увеличение количества нейтрофилов - встречается при инфекционных и
гнойно-воспалительных процессах.
При этом в периферической крови
нередко появляются незрелые формы (метамиелоциты, иногда миелоциты), увеличивается количество палочкоядерных нейтрофилов. Такое омоложение нейтрофилов носит название “ сдвиг влево”.
Индекс сдвига можно высчитать по формуле:
миелоциты + метамиелоциты + палочкоядерные
Индекс сдвига = -------------------------------------------------------
сегментоядерные нейтрофилы
В норме индекс сдвига составляет 1/16 (0,06). Чем выше индекс сдвига, тем более сильно выражено “омоложение” состава нейтрофилов.
Слайд 55нейтрофилез – уровень нейтрофилов
более 6 · 10 9 /л .
Перераспределительный:
эмоциональный
пищеварительный
миогенный
физиотерапевтический
на фоне лечения глюкокортикоидами
Реактивный
инфекции
воспаление
некроз
интоксикация
гипоксия
опухоли.
Слайд 56Нейтропения - снижение количества нейтрофилов менее 0,5х109/л - является признаком
угнетения гранулоцитопоэза, наблюдается при некоторых инфекционных заболеваниях - вирусный гепатит,
брюшной тиф, бруцеллез, краснуха, ветряная оспа, грипп, токсоплазмоз, СПИД.
Встречается при агранулоцитозе и апластических состояниях, при воздействии физических и химических агентов (ионизирующая радиация, лучевое и цитостатическое лечение, бензол, сульфаниламиды, противосудорожные и антитиреоидные препараты, транквилизаторы, люминал и др.).
Слайд 58Клинико-диагностическое значение эозинопении
1 фаза воспалительного процесса
при тяжелых гнойных инфекциях
Шок
Стресс
Эклампсия
В периоде
родов
Интоксикация различными химическими соединениями, тяжелыми металлами
Слайд 59Клиническое значение базофилии (более 150\мкл)
Эти клетки являются источником медиаторов, запускающих
анафилактоидную реакцию немедленного типа, поэтому базофилия встречается при
аллергических реакциях,
Воспалительные процессы - ранняя фаза ревматизма, ревматоидный артрит, язвенный колит
ХМПЗ (хроническом миелолейкозе, миелофиброзе, эритремии)
Вирусные заболевания - ветрянка, грипп
Хронические инфекции – туберкулез
Дефицит железа
рак
Слайд 60ЛИМФОЦИТОЗ –
уровень выше 4,0 · 109 / л
в возрасте
после 4-х лет
с 4-5 дней до 4-5 лет
Патология в
этом возрастном
периоде при повышении
лимфоцитов в формуле > 65%.
ЛИМФОЦИТОЗ ФИЗИОЛОГИЧЕСКИЙ
Слайд 61 ПРИЧИНЫ ЛИМФОЦИТОЗА
некоторые бактериальные инфекции (коклюш, иерсиниоз, феллиноз)
лимфотропные инфекционные заболевания
(инфекционный мононуклеоз, инфекционный лимфоцитоз, цитомегаловирус, аденовирус)
иммунокомплексные болезни (тиреотоксикоз, язвенный колит,
болезнь Крона, васкулиты)
детские инфекции (ветряная оспа, скарлатина. краснуха, гепатит)
Слайд 62ЛИМФОПЕНИЯ
– уровень лимфоцитов ниже 1,2 · 10 9 /
л
на фоне лечения глюкокортикоидами
СПИД
лимфогрануломатоз, лимфосаркома
хронические инфекции (туберкулёз, саркоидоз)
диссеминированная системная красная
волчанка
Слайд 63МОНОЦИТОЗ –
уровень моноцитов выше 0,8 · 109 /ë
Возрастные нормативы
моноцитов:
новорожденные 5-6%
1 неделя жизни 6-9%
6 месяцев – 6 лет 5-7%
старше 6 лет
4-5%
инфекционный мононуклеоз
иерсиниоз
коревая краснуха
туберкулёз
хронические вялотекущие воспалительные процессы
спленэктомия
моноцитарный лейкоз
Слайд 64Тромбоциты, иначе называемые кровяными пластинками, не являются истинными клеточными образованиями,
а представляют собой отшнуровавшиеся части протоплазмы мегакариоцитов костного мозга.
Тромбоцит -
безъядерная сферическая клетка диаметром 2-4 мкм, средний объем 7,5 мкм3. Популяция тромбоцитов неоднородна. Различают зрелые тромбоциты (87%), юные (незрелые - 3,2%), старые (4,5%), формы раздражения (2,5%).
Слайд 65Основные функции тромбоцитов:
Ангио-трофическая функция
Адгезивно-агрегационная функция
Сорбционно-транспортная функция
Активация плазменного
гемостаза
Ретракция кровяного сгустка
Слайд 67Тромбоциты
Время циркуляции тромбоцитов –10 сут.
Грануломер ( в составе гранул –
АТФ, фосфолипиды, серотонин, гистамин, катионные белки,
фактор активации
фибробластов, ферменты, трансформирующий фактор роста и др.)
Слайд 69Биохимический анализ крови -
анализ, позволяющий определить функцию печени, почек, активный воспалительный
процесс, ревматический процесс, а также нарушение водно-солевого обмена и дисбаланс
микроэлементов.
Слайд 70Биохимический анализ крови необходимо производить натощак. после 8-12 часов голодания
(обычно разрешается пить воду). Результаты анализа крови, взятой через 3-4
часа после завтрака, будут отличаться от показателей «натощак»; если же кровь берут через 3-4 часа после обеда, то показатели будут отличаться еще в большей степени.
Слайд 71Результаты анализа
Параметры:
Глюкоза — норма 3,30-5,50 миллимоль на литр. Повышенный уровень
глюкозы свидетельствует об угрозе сахарного диабета или нарушении толерантности к
глюкозе, что требует консультации эндокринолога.
Слайд 72Мочевина — норма мочевины — 2,5-8,3 миллимоля на литр. Повышение нормы говорит
о плохой выделительной работе почек и нарушении фильтрации. Нарастание содержания
мочевины в крови до 16—20 ммоль/л (в расчете на азот мочевины) классифицируется как нарушение функции почек средней тяжести, до 35 ммоль/л — как тяжелое; свыше 50 ммоль/л — очень тяжелое, с неблагоприятным прогнозом. При острой почечной недостаточности концентрация мочевины в крови может достигать 50—83 ммоль/л.
Слайд 73Остаточный азот крови (небелковый азот крови) — азот веществ, остающихся после
удаления белков плазмы крови. Остаточный азот состоит из азота мочевины
(50 %), азота аминокислот (25 %), мочевой кислоты (4 %), креатина (5 %), креатинина (2,5 %), эрготианина (8 %), аммиака и индикана (0,5 %); 5 % азота содержится в полипептидах, глутатионе, билирубине и других небелковых соединениях. В норме содержание остаточного азота в сыворотке крови колеблется от 14,3 до 28,6 ммоль/л.
Слайд 74Креатинин — рассматривается в комплексе с мочевиной. Норма креатинина — 44-106 микромиллилитров
на литр. Как и мочевина, креатинин говорит о работе почек.
Холестерин — норма — 2,6-6,7 миллимоля на литр. Высокий уровень холестерина сигнализирует об угрозе атеросклероза.
Слайд 75Общий билирубин — в норме он не должен быть выше 22,2
микромиллилитра на литр. Этот показатель растет при гепатитах и других
заболеваниях печени и желчевыводящих путей, например ферментопатии (синдром Жильбера).
Прямой билирубин
Слайд 76Общий белок — определяет уровень белка в сыворотке крови. Его норма —
62-83 грамма на литр. Если человек плохо питается, истощен, уровень
белка резко понижается. То же самое бывает, когда у человека болезнь, при которой не усваивается белок.
Слайд 77АлАт (Трансаминаза АЛТ) — фермент используемый для оценки функции печени. Норма
АЛТ зависит от оборудования, на котором производится исследование.
АсАТ (Трансаминаза
АСТ) — фермент используемый для оценки функции печени. Норма АСТ зависит от оборудования, на котором производится исследование (N= 0.1-0.45 миллимоля на литр). Высокое содержание АЛТ и АСТ бывает при гепатитах.
Слайд 78Липаза — фермент секретируемый в основном поджелудочной железой. Его уровень в
крови повышается при воспалении/повреждении поджелудочной железы.
Амилаза — фермент секретируемый в
основном поджелудочной железой и слюнными железами. Его уровень в крови повышается при воспалении/повреждении поджелудочной железы.
Слайд 79Гамма-ГТ — Гамма-глутамилтрансфераза, фермент используемый для оценки функции печени.
Антистрептолизин-О — АСЛ-О
представляет собой антитела к антигену (стрептолизину) бета-гемолитического стрептококка группы А.
Используется в диагностике ревматизма.
Слайд 80Ревмофактор (ревматоидный фактор) — вид антител, находящийся в крови многих больных
аутоиммунными заболеваниями (ревматизм, ревматоидный артрит, системная красная волчанка, склеродермия и
др.).
СРБ (С-реактивный белок) — неспецифичный индикатор воспаления в организме.
Слайд 81Щелочная фосфатаза — катализирует отщепление фосфорной кислоты от ее органических соединений;
название получила в связи с тем, что оптимум рН щелочной
фосфатазы лежит в щелочной среде (рН 8,6-10,1). Фермент расположен на клеточной мембране и принимает участие в транспорте фосфора. Катализирует гидролиз сложных эфиров фосфорной кислоты и органических соединений. Самая высокая концентрация ЩФ обнаруживается в костной ткани (остеобластах), гепатоцитах, клетках почечных канальцев, слизистой кишечника и плаценте. Увеличение активности щелочной фосфатазы сопровождает рахит любой этиологии, болезнь Педжета, костные изменения, связанные с гиперпаратиреозом.